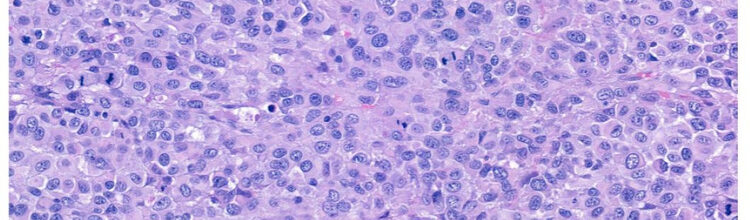

My story
Hi all,
I'm back and so is my cancerous friend!!!
This is the second time I have participated in the #100MilesinMay challenge, and as always I would appreciate any support you can offer. Let me give you an update.
I completed a year of immunotherapy (Keytruda) in March 2025 and was all clean until September when the little beast returned. I undertook a small surgery to remove the singular lymph node that was positive for cancer, leaving around 6 or 7 lymph nodes left in my right armpit. The total number of lymph nodes in one armpit varies per person but typically start around 20. So far I have had >10 of these little things removed from my right armpit over three different surgical procedures (a fourth surgery coming soon). Anyhow, the surgery in September was not successful as my beast returned just before Christmas. After the Christmas holiday I started a new course of combined immunotherapy but 3 months later (March 2026) the lymph node has started to grow.
So what's next? I can update you once I have spoken with my oncologist in April but likely a new treatment and the fourth surgery.
In the meantime I have decided to crack on with #100MilesInMay so why not donate a small amount to my challenge, and then once I've update my page you can come back and donate a little more (hehe).
This time my challenge will be to walk the 100 miles. I will include a couple of long walk (Brampton Valley way in Northampton, 14 miles & Stortford to London, ~30 miles along the riverbanks) which will help me rack up a bunch of miles and then I'll squeeze in the rest during the week and weekends . . . sounds simple (but I know it won't be).
Thanks for checking out the page and I'm grateful for your donation.
James
Show more
Thank you for checking out my page. Making a donation is fast, easy and secure thanks to Give as you Live Donate. They'll take your donation and pass it onto Skcin and Melanoma Focus.